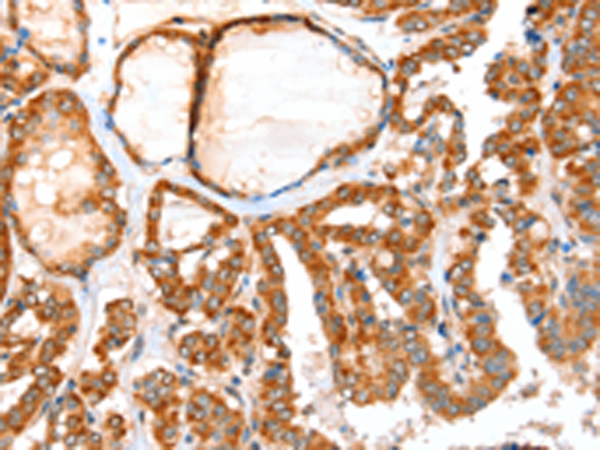

-
分类: 科研抗体货号: P07752别名:应用: IHC反应种属: Human
-
分类: 科研抗体货号: P07720别名: MKS3; JBTS6; NPHP11; TNEM67; MECKELIN应用: WB,IHC反应种属: Human, Mouse, Rat
-
分类: 科研抗体货号: P07736别名: PHARC; ABHD12A; BEM46L2; C20orf22; dJ965G21.2应用: IHC反应种属: Human, Mouse, Rat
-
分类: 科研抗体货号: P07751别名: ACOX; SCOX; PALMCOX应用: IHC反应种属: Human, Mouse, Rat
-
分类: 科研抗体货号: P07719别名: Fz4; EVR1; FEVR; Fz-4; FzE4; GPCR; hFz4; CD344; FZD4S应用: WB反应种属: Human, Mouse, Rat
-
分类: 科研抗体货号: P07735别名: ABH2应用: WB反应种属: Human, Mouse
-
分类: 科研抗体货号: P07750别名: BFIT; THEA; THEM1; STARD14应用: WB,IHC反应种属: Human, Mouse
-
分类: 科研抗体货号: P07718别名:应用: WB反应种属: Human
-
分类: 科研抗体货号: P07734别名: ABH; ABH1; alkB; hABH; ALKBH应用: WB反应种属: Human, Mouse
-
分类: 科研抗体货号: P07749别名: ACT; ACH1; BACH; LACH; LACH1; hBACH; CTE-II应用: IHC反应种属: Human

鄂公网安备42018502007531号
鄂公网安备42018502007531号

